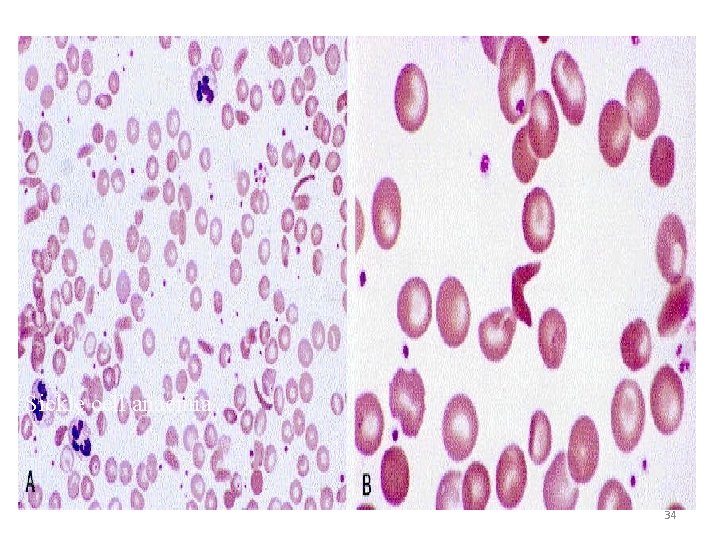
Sickle cell anaemia 34

SICKLE CELL ANEMIA 1 What Is Sickle Cell

- Slides: 37
SICKLE CELL ANEMIA 1
What Is Sickle Cell Anemia? • An inherited disease of RBC • Abnormal hemoglobin – Hb. S n RBC become sickle-shaped • anemia • polymerization of hemoglobin leads to a cascade of effects decreasing blood flow 2
Sickle Cell disease Normal RBC are smooth & round. They move easily through blood vessels. Sickle-shaped cells don’t move easily. They’re stiff, sticky, hard & irregularly shaped tend to form clumps & get stuck in blood vessels. The clumps of sickle cell block blood flow Blocked blood vessel can cause pain, & organ damage. 3
4
Sickle cell anemia • a point mutation in the 6 th codon of the beta globin gene (chromosome 11). • Valine is substituted for glutamic acid • Homozygous – sickle cell disease • Heterozygous – sickle cell trait 5
Pathogenesis • When sickle haemoglobin (Hb. S) gives up its oxygen to the tissues, Hb. S sticks together – Forms long rods inside RBC – RBC become rigid, inflexible, sickle-shaped – Unable to squeeze through small blood vessels, instead block small blood vessels – Less oxygen to tissues of body • RBCs containing Hb. S have a shorter lifespan – Normally 120 days – Chronic state of anaemia 6
Hemolysis: The anemia in SCD is caused by red cell destruction (hemolysis), . The production of red cells by the bone marrow increases dramatically, but is unable to keep pace with the destruction. Vaso-occlusion: Occurs when the rigid sickle shaped cells fail to move through the small blood vessels, blocking local blood flow to a microscopic region of tissue. Amplified many times, these episodes produce tissue hypoxia. The result is pain, and often damage to organs. 7
• Factors promoting deoxygenation § Hypoxia § Acidosis § Hypertonicity § Temperature >37 degree celsius
Sickle Cell Trait § Sickle haemoglobin (S) + Normal haemoglobin (A) Adequate amount of normal Hb (A) § RBC remain flexible § Carrier § Do Not have the symptoms of the sickle cell disorders, with 2 exceptions 1. Pain when Less Oxygen than usual (scuba diving, activities at high altitude (12, 000 ft), general anaesthesia) 2. Kidney - hyposthenuria 9
Three common types of Sickle Cell Disorders 1. Sickle Cell Anemia (sickle cell disease) § Sickle haemoglobin (Hb. S) + Sickle haemoglobin (Hb. S) § Most Severe – No Hb. A 10
Other Disorders Other types of Hb combine with sickle Hb 2. Hemoglobin S-C disease – Sickle haemoglobin (Hb. S) + (Hb. C) 3. Hemoglobin S-Beta thalassemia – Beta thalassaemia gene reduces the amount of Hb. A that can be made – Sickle haemoglobin (Hb. S) + reduced Hb. A 11
Sickle Cell Diseases SCD Genotype • • Genotype Sickle cell anemia (SS) Sickle Hb C disease (SC) Sickle S beta plus (Sβ+ thalassemia ) Sickle Beta zero (Sβ° thalassemia) Genotype prevalence • 65% • 25% • 8% • 2% 12
Sickle Cell Anemia vs. Sickle Cell Trait • People who have sickle cell anemia inherit two copies of sickle cell gene, one from each parent. • People with sickle cell trait don’t have the condition, but they have one of the genes that cause the condition. • People with sickle cell anemia and sickle cell trait can pass the gene on when they have children. 13
Signs and Symptoms Present at birth, many infants doesn’t show signs until after 4 months of age Anemia: Fatigue (tiredness), pale skin and nail beds, jaundice, and shortness of breath Pain (Sickle Cell Crisis): Hypoxia Sudden episode of pain throughout the body. Common sites: bones, lungs, abdomen, and joints. 14
COURSE § Typically appear during infant's first year § 1 st symptoms: dactylitis & fever (6 mo-2 yrs) § Pain in the chest, abdomen, limbs and joints § Enlargement of the heart, liver & spleen § Frequent upper respiratory infections § Chronic anemia as children grow older § Over time Sickle Cell sufferers can experience damage to organs such as liver, kidney, lungs, heart and spleen § Can result in death 15
§ Infectious complications § Bacterial Sepsis, meningitis, pneumonia, osteomyelitis, UTI § Prominent early in life § Leading cause of morbidity and mortality § vaccination for childhood illnesses, the use of prophylactic antibiotics, and aggressive diagnosis and treatment of febrile events 16
Recurrent Pain Episodes or Sickling Crises n Occur at any age but particularly frequent in late adolescence & early adult life § Unpredictable § Red Blood Cells get stuck in the small veins & prevent normal blood flow § Characterized by severe pain in the back, chest, abdomen, extremities, and head § Highly disruptive to life § Most common reasons for individuals to seek health care 17
Triggers of Pain § § § Infections dehydration Over-exertion Cold weather, cold drinks, swimming Bangs, bumps, bruises & strains Stress triggers pain in adults, but does not seem to do so in children. 18
Hand Foot Syndrome - Dactylitis • Early complication • Highest incidence 6 months to 2 years • Painful swelling of hands and feet • Treatment involves fluids & pain medication 19
Splenic Sequestration • • Sudden trapping of blood within the spleen Usually occurs in infants under 2 years of age Spleen enlarged on physical exam Circulatory collapse and death • Recurrence very common (50%) • Associated with high mortality (20%) 20
Acute Chest Syndrome A leading cause of death in sickle cell disease Clinically: Acute onset of fever, respiratory symptoms, new infiltrate on chest x-ray Causes – Infection – Fat emboli – Lung infarct Since you cannot distinguish between acute chest syndrome and pneumonia clinically there is no change in treatment. 21
Stroke • 8 to 10% of children “Silent Stroke” in 22% of children Treatment: Chronic transfusion therapy to maintain sickle hemoglobin at or below 30% 22
Stroke • Intracranial hemorrhage – More common in adults • Sequela overt & “silent strokes” – Paralysis – Neuropsychologic changes • Visual-spatial impairment • Impaired memory • Poor impulse control 23
Anemia – Jaundice Chronic Anemia Associated with fatigue, irritability, jaundice, pain, delayed puberty • Common • starting in the first year of life • Decreased lifespan of sickle red cells – Hemolysis – Anemia – Hyperbilirubinemia – Reticulocytosis 24
25
Renal Disease – Decreased ability to concentrate urine – Decreased ability to excrete potassium – Inability to lower urine p. H normally – Hematuria / papillary necrosis 26
Renal Disease • Proteinuria/Nephrotic syndrome • 40% of SCD patients with nephrotic syndrome develop end-stage renal disease • Occurs in ~ 20% of all patients • Occurs in 4. 5% of all pediatric 27
Gall Bladder and Liver • Gall stones and biliary sludge – Monitor by ultrasound every 1 -2 years • Cholestasis – May progress, leading to bleeding disorders or liver failure • Iron overload – Due to chronic transfusions • Chronic hepatitis 28
§ Bone disease § Early risk is primarily from osteomyelitis § Infectious usually painful inflammatory disease of bone often of bacterial origin and may result in bone tissue death § Avascular necrosis of the femur and humerus § Death of bone tissue due to disrupted blood supply § Marked by severe pain in the affected region and by weakened bone that may flatten and collapse 29
Leg Ulcers • Occurs in about 25% of all patients • Predominantly males – Incidence increased with • Age • Decreased hemoglobin • Recurrence rate is ~ 75% 30
• Ophthalmic complications – Proliferative retinopathy, – vitreous hemorrhage, – retinal detachment 31
CRISES • • Vaso occlusive / infarctive / painful Aplastic Sequestration Hemolytic 32
• Lab evaluations: – CBC with differential and reticulocyte count, urinalysis, renal & liver function 33
Sickle cell anaemia 34
Sodium Metabisulfite Method Principle • When a drop of blood is sealed between a cover slip and a slide, the decline in oxygen tension due to oxidative processes in the blood cells leads to sickling. • blood drop and a chemical reducing agents such as sodium metabisulfite. This rapidly reduces oxyhemoglobin to reduced hemoglobin, then this will be accelerate sickling.
Hemoglobin solubility test • Principle: • Decreased solubility of deoxygenated Hb. S forms the basis for this test. • Method: • Blood is added to reducing agent Sodium dithionate and lysing agent that release hemoglobin from RBC. • The whole mixture is incubated for 15 minutes • Deoxy. Hb. S is insoluble and precipitate in the solution lead to turbidity.
Hemoglobin Electrophoresis Patterns